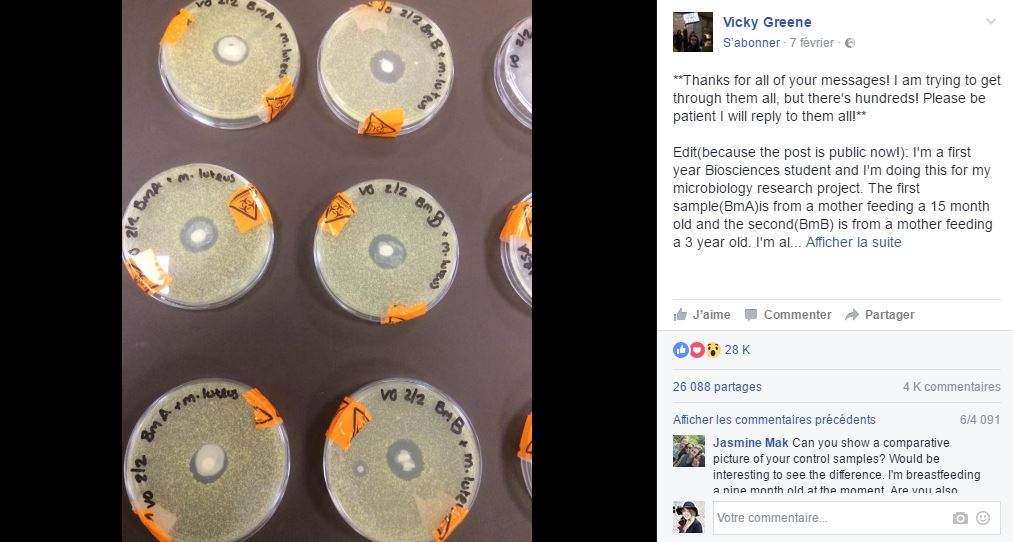

Le lait maternel est une nouvelle fois la star du web. Et pour cause, postée sur Facebook il y a moins d’une semaine par Vicky Greene, étudiante en biologie, une photo de ladite substance a été aimée et partagée plus de 26 000 fois. Cette publication rappelle le succès d’une vidéo de trente secondes montrant une goutte de lait maternel filmée au microscope qui avait fascinée les internautes en quelques jours seulement.
Les super-pouvoirs du lait maternel
L’OMS (Organisation mondiale de la santé) préconise d’allaiter les six premiers mois de bébé. Et pour cause, même si chaque maman est libre de donner le sein ou pas, le lait maternel possède certaines qualités inégalables comme la présence d’anticorps par exemple. Ainsi, lorsque son enfant est exposé à un virus, la maman produit des anticorps qui sont transmis au petit bout grâce à l’allaitement. Et, même si des études ont montré que les bébés allaités sont moins susceptibles d’attraper des virus, s’ils les contractent, ils sont d’autant plus capables de les combattre rapidement grâce au lait maternel.
Partagé sur Facebook par Vicky Greene, un cliché prouvant une nouvelle fois les bienfaits du lait maternel a impressionné les internautes. On y découvre neuf boîtes de Petri contenant la bactérie Micrococcus luteus dans lesquelles l’étudiante en biologie a ajouté des échantillons de lait maternel d’une maman d’un bébé de 15 mois et d’une maman d’un enfant de 3 ans. Et les résultats sont étonnants ! On remarque que là où le lait a été placé, la bactérie a complètement disparu. Dans la publication, Vicky Greene a précisé qu’elle avait obtenu des résultats similaires avec la bactérie escherichia coli (E. Coli) et le staphylococcus aureus résistant à la méticilline (SARM). Le fait que Vicky Green ait analysé le lait maternel de deux mamans avec des enfants d’âge différents prouve que ses bienfaits ne se limitent pas au-delà d’un certain âge. Une chose est sûre, le lait maternel n’a pas fini de nous surprendre !